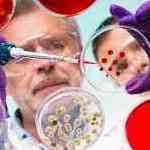
Vivian James

-
3 Posts
-
1 Photos
-
0 Videos
-
Female
-
Followed by 0 people
Recent Updates
-
Unlocking Molecular Mysteries with Single Particle Analysis (SPA)For decades, visualizing the intricate machinery of life at high resolution, often enabling near-atomic insights: growing perfectly ordered crystals of biological molecules. This bottleneck left a vast landscape of vital proteins, especially flexible complexes and delicate membrane-bound targets, shrouded in mystery and considered structurally intractable and difficult to characterize at high...0 Comments 0 Shares 593 Views 0 ReviewsPlease log in to like, share and comment!
-
Cryo-EM's Next Frontier: How Integrated Services Turn Vision into StructureBeyond the Freeze Frame: How Cryo-EM is Capturing Biology in Action For centuries, the intricate machines that power life—the proteins, viruses, and molecular complexes—operated in the dark. Scientists could infer their roles, but visualizing their precise, three-dimensional forms, especially in their natural, dynamic states, was a monumental challenge. This all changed with what...0 Comments 0 Shares 781 Views 0 Reviews
-
0 Comments 0 Shares 429 Views 0 Reviews
More Stories